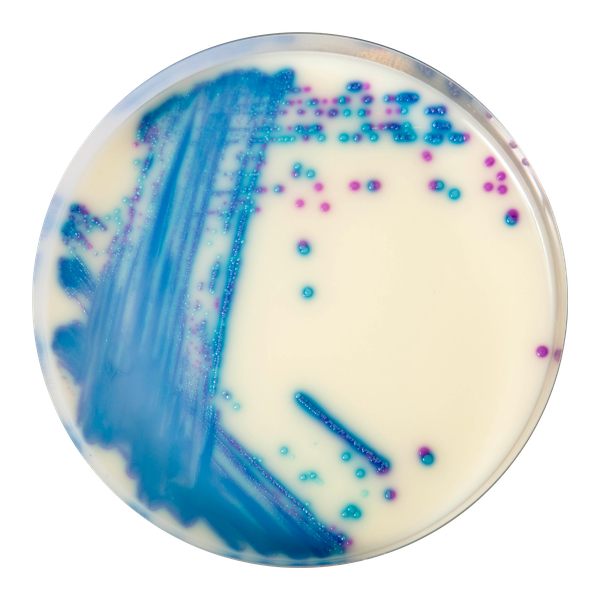
CHROMagar™ VRE
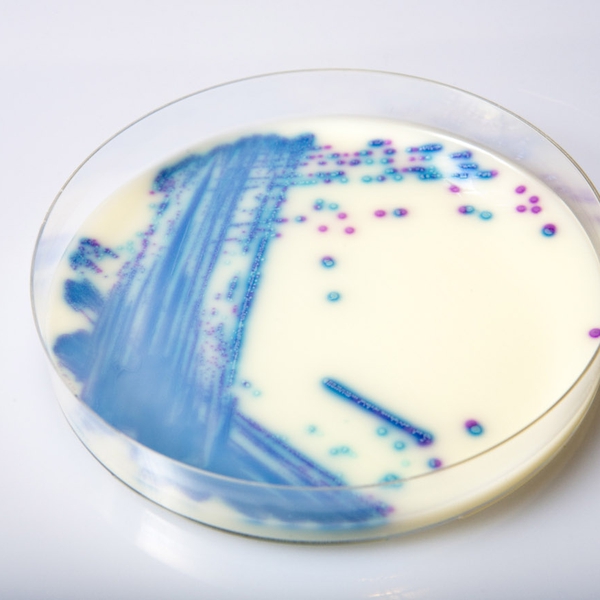
CHROMagar™ VRE

Hình thái khuẩn lạc

ERV. faecalis/ERV. faecium
Hồng đến tím nhạt

E. gallinarum/E. casseliflavus
Màu xanh hoặc bị ức chế
Hiệu năng
Hiệu năng
Có hai loại kháng vancomycin trong Enterococci. Loại đầu tiên là kháng tự nhiên (chủ yếu là loại Van C nhưng cũng có Van D, Van E, Van F, v.v.) tìm thấy trong E. gallinarum và E. casseliflavus/E. flavescens và thể hiện một mức độ kháng thấp đối với vancomycin. Loại kháng vancomycin thứ hai trong enterococci là kháng thu nhận (các loại Van A & Van B), thường thấy trong E. faecium và E. faecalis. Do đó, để tránh sự lan truyền của kháng này đến các tác nhân gây bệnh nghiêm trọng hơn (ví dụ, S. aureus), rất quan trọng để nhanh chóng phát hiện sự hiện diện của bất kỳ hai loại này trong bệnh nhân, và chính xác phân biệt chúng với các Enterococci khác.
Những nhiễm trùng vancomycin kháng Enterococcus (VRE) đặc biệt tấn công mạnh và đã được liên kết với tỷ lệ tử vong lên tới 60 % đến 70 %.
Mục đích sử dụng :
CHROMagar™ VRE là một môi trường chromogen chọn lọc và phân biệt, chứa 6 mg/L vancomycin, dùng để phát hiện trực tiếp định tính tình trạng mang gen VRE loại vanA/vanB truyền được với Enterococcus faecium kháng vancomycin và Enterococcus faecalis (VRE) để hỗ trợ trong việc ngăn chặn và kiểm soát VRE trong các cơ sở y tế. Xét nghiệm được thực hiện với gạc trực tràng và phân của bệnh nhân để sàng lọc tình trạng mang VRE. Kết quả có thể được diễn giải sau 24 giờ ủ hiếu khí ở 35-37 ° C.
Môi trường này cũng có thể được sử dụng như một chỉ số cảnh báo sớm cho các xét nghiệm chẩn đoán nhiễm trùng để báo hiệu sự hiện diện có thể có của vi khuẩn kháng nhiều thuốc. Cách sử dụng này không thay thế các giao thức của tổ chức. CHROMagar™ VRE không nhằm mục đích chẩn đoán nhiễm trùng VRE hoặc hướng dẫn hoặc giám sát điều trị cho các nhiễm trùng. Thiếu sự phát triển hoặc không có các khuẩn lạc màu hồng trên CHROMagar™ VRE không loại trừ sự hiện diện của VRE. Cần nghiên cứu thêm, test tính nhạy cảm và gõ kiểu dịch tễ trên các khuẩn lạc nghi ngờ.
1. Công cụ đơn giản, nhanh chóng và đáng tin cậy : cho phát hiện trực tiếp các chủng VRE có kháng truyền: đây là một sự hỗ trợ quý giá trong việc thực hiện các biện pháp kiểm soát thích hợp để ngăn chặn sự lan truyền của VRE.
2. Màu sắc khuẩn lạc đậm: Trong CHROMagar™ VRE, các chủng VRE faecalis và VREfaecium có thể dễ dàng phân biệt thông qua màu sắc khuẩn lạc. Ngược lại, trong môi trường thạch cổ điển để phát hiện VRE (Bile Esculine Agar bổ sung vancomycin):
(I) không có sự phân biệt giữa E. faecalis/E. faecium; (II) thường dẫn đến dương tính giả với các vi khuẩn thủy giải esculine khác (như Lastococcus, Pediococcus...); (III) đám "mây" đen làm cho việc đọc đĩa khó khăn cũng như việc chọn đúng khuẩn lạc cho các xét nghiệm xác nhận tiếp theo.
3. Sự linh hoạt : CHROMagar™ VRE được cung cấp với thời gian lưu trữ hơn 18 tháng. Điều này cho phép sử dụng linh hoạt, dù trong tình huống dịch bệnh cần sàng lọc nhiều bệnh nhân hay giám sát ngẫu nhiên các môi trường nuôi cấy.

Thành phần

Tài liệu kỹ thuật
Công bố khoa học
2023
Comparison of Five Different Selective Agar for the Detection of Vancomycin-Resistant Enterococcus faecium
📄 Publication2013
Performance of CHROMagar VRE medium for the detection of Airborne Vancomycin-resistant/sensitive Enterococcus species
📄 Publication2012
Evaluation of CHROMagar compared with enterococcosel broth for the isolation of vancomycin resistant enterococci
📄 Publication2012
A novel method “CHROMagar” for screening vancomycin-resistant enterococci (VRE) isolates
📄 Publication2011
Evaluation of Three Chromogenic Media for Detection of Vancomycin-Resistant Enterococci in a tertiary-care Hospital M.L. Miller et al.
📄 Publication2011
Evaluation of Three Commercial Chromogenic Media and BEAA + van 6ug/mL for the Detection of Vancomycin-Resistant Enterococcus (VRE)
📄 Publication2011
Evaluation of Broth Enrichment for the Detection of Vancomycin Resistant Enterococci on Two Chromogenic Media
📄 Publication2009
Evaluation of a ColorexTM chromogenic media and Bile-esculin azide agar with 6ug vancomycin for the detection of Vancomycin Resistant Enterococcus faecalis and Enterococcus faecium (VRE)
📄 Publication2009
Evaluation of Chromogenic Agar for Screening Vancomycin-resistant Enterococcus (VRE)
📄 Publication2009
Comparison of two chromogenic media for selective isolation of vancomycin-resistant enterococci from stool specimens
📄 Publication2008
Evaluation of Two Chromogenic Media for the Isolation of VRE (Vancomycin Resistant Enterococci)
📄 Publication2008
Evalucion de un Medio Cromogénico (CHROMagar) Para La Detection de Enterococos Resistentes a Vancominica (EVR) a partir de Hisopados Rectales
📄 Publication2007
A novel Chromogenic Agar Medium for the Detection of Vancomycin Resistant Enterococci (VRE)
📄 Publication2020
A genomic epidemiology study of multidrug-resistant Escherichia coli, Klebsiella pneumoniae and Acinetobacter baumannii in two intensive care units in Hanoi, Vietnam
📄 Publication

Xem thêm